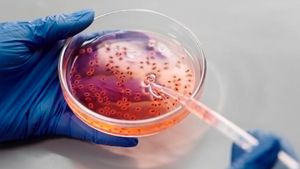
Kasus Infeksinya Meningkat di Amerika Serikat, Apa Itu Nightmare Bacteria?

JAKARTA - Dokter spesialis anak dr. Mulya Rahma Karyanti, SpA(K) mengatakan antibiotik tidak dianjurkan untuk dibeli secara bebas tanpa resep dokter karena bisa mengakibatkan bakteri dalam tubuh menjadi kebal.
“Bisa menyebabkan bakteri lama mati dan tersisa bakteri yang kebal dan ini bisa bertahan hidup dan bisa menyebabkan penyakit yang lebih berat sampai mengancam nyawa," ucapnya dalam webinar mengenai Penanganan Demam pada Anak dalam rangka HUT RSCM ke 103 tahun yang diikuti secara daring di Jakarta, Antara, Jumat, 4 November.
Jadi tidak dianjurkan untuk memberikan antibiotik dengan membeli langsung di apotek,
Antibiotik hanya boleh diberikan oleh dokter umum atau dokter gigi dan harus mengikuti aturan pemakaian agar efektif membunuh bakteri.
Dan juga tidak dianjurkan menggunakan antibiotik yang sama sisa pemakaian karena bisa jadi penyakit yang diderita sudah berbeda.
“Cara minumnya juga harus diikuti sesuai aturan dan harus sampai habis. Jika sudah mendapat antibiotik jangan berbagi karena penyakitnya beda, belum berat badannya juga beda,” ucap Mulya.
Aturan pemakaian obatnya juga harus diperhatikan. Misalkan instruksi obat diminum untuk tiga kali sehari, maka sebaiknya diberikan setiap interval delapan jam.
“Misalnya jam enam pagi, jam dua siang dan jam sepuluh malam. Karena nanti kadar obat yang lebih dari delapan jam tidak efektif membunuh bakteri, jadi tetap harus diikuti kalau pemberian tiga kali artinya dibagi dalam delapan jam, dua kali sehari diberikan dalam interval 12 jam,” jelasnya.
Dokter yang praktik di RSU Bunda Margonda ini menjelaskan obat antibiotik tidak perlu selalu diberikan pada anak jika demam karena sebagian besar virus dapat sembuh dengan sendirinya.
“Sebagian besar 90 persen penyebab demam pada anak adalah virus, jadi itu dapat sembuh sendiri. Sebaiknya kalau memang dua sampai tiga hari demam tidak membaik sebaiknya berobat ke dokter,” ucapnya.
Mulya mengatakan bahwa demam atau kenaikan suhu tubuh merupakan reaksi normal antibodi dalam tubuh untuk merespon infeksi bakteri maupun jamur.
BACA JUGA:
Ketika anak habis bermain atau berlarian, suhu tubuh juga bisa naik dan belum tentu dapat diartikan demam.
“Jadi anak-anak habis berlarian juga demam itu reaksi tubuh yang normal, tujuannya agar antibodi tubuhnya bekerja lebih optimal. Sebenarnya tidak terlalu bahaya kecuali ada riwayat kejang demam yang bisa terjadi pada anak-anak yang suhunya meningkat.,” ucap Mulya.